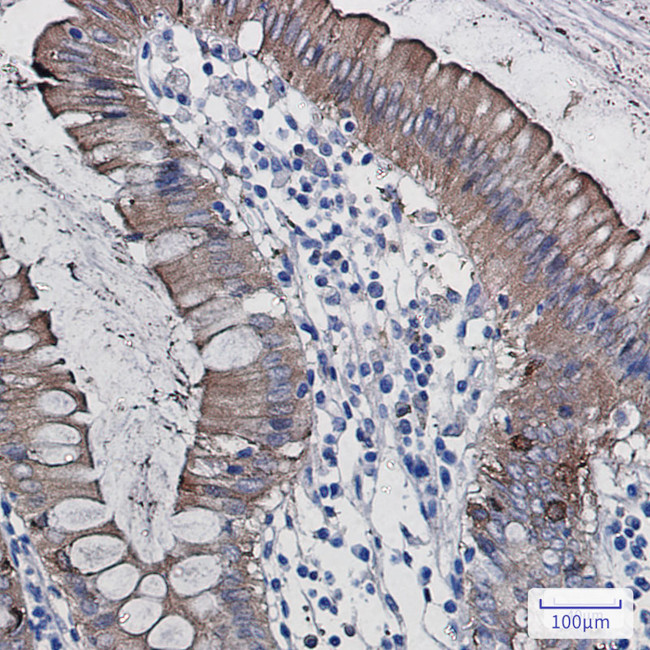
SCIN Antibody in Immunohistochemistry (Paraffin) (IHC (P))

Search
Invitrogen
SCIN Recombinant Rabbit Monoclonal Antibody (K01_1Y16)
{{$productOrderCtrl.translations['antibody.pdp.commerceCard.promotion.promotions']}}
{{$productOrderCtrl.translations['antibody.pdp.commerceCard.promotion.viewpromo']}}
{{$productOrderCtrl.translations['antibody.pdp.commerceCard.promotion.promocode']}}: {{promo.promoCode}} {{promo.promoTitle}} {{promo.promoDescription}}. {{$productOrderCtrl.translations['antibody.pdp.commerceCard.promotion.learnmore']}}
产品信息
MA563616
种属反应
宿主/亚型
Expression System
分类
类型
克隆号
抗原
偶联物
形式
浓度
规格
纯化类型
保存液
内含物
保存条件
运输条件
RRID
产品详细信息
Immunogen sequence: ESLKSAKMYL ETDP
靶标信息
The SCIN gene, also known as scinderin, encodes for a calcium-dependent actin filament-severing protein that is involved in the regulation of the cytoskeleton. It plays a significant role in actin filament dynamics, influencing cellular processes such as cell shape, motility, secretion, and division. SCIN has been identified as a novel oncogene, with its abnormal expression strongly correlated to various cancers, including glioma and uterine corpus endometrial carcinoma. Specific mutations like S673F and S381Y in SCIN are linked with poor prognosis and are potential targets for cancer diagnosis, prognosis, and treatment strategies.
仅用于科研。不用于诊断过程。未经明确授权不得转售。
篇参考文献 (0)
生物信息学
蛋白别名: Adseverin; Scinderin; unnamed protein product
基因别名: KIAA1905; SCIN
UniProt ID: (Human) Q9Y6U3
Entrez Gene ID: (Human) 85477